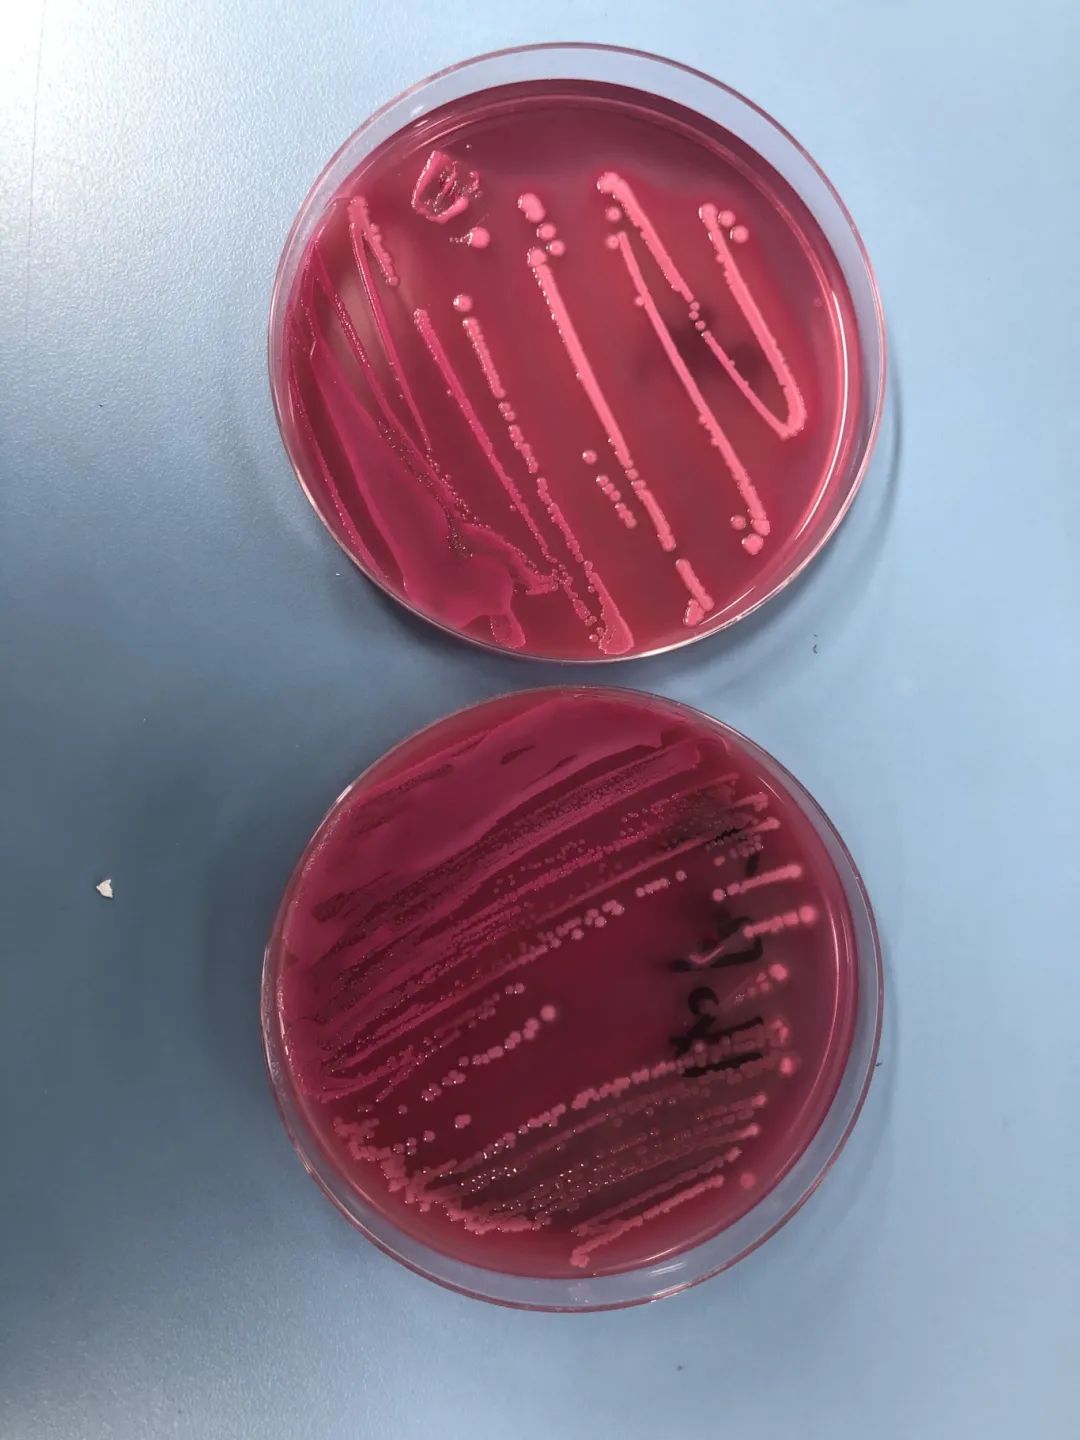
图片

一张细菌培养结果需要等多久?一起走进检验科微生物室吧!
在门诊经常会有患者问:“为什么要做细菌培养?为什么要等好几天才出报告?”
简单的回答:为了明确致病菌及指导临床医生用药。多久出报告,听检验科来细说。
一张微生物检验报告要准确及时地报告,是需要经过以下几个流程:
第一天:标本的采集、接种(2小时内送检);
第二天:标本的观察、鉴定药敏,如果菌落分纯(继续培养24小时)
第三天:报告结果,发出报告。
在工作中,微生物报告一般都需要3-5天,特殊菌培养需要更久!所以,经常会碰到患者来询问为什么细菌培养出结果这么久?
如果把标本里(血、尿、粪便等)隐藏的细菌接种到合适的培养皿,经过18-48小时,生长形成菌落。再进行细菌种类鉴定及药敏试验,这个过程需要等待几天,也就是标本为什么要等这么久。


送检的标本可以是深咳痰液、清晨清洁中段尿液、脑脊液或是高烧寒颤时抽取的血液,也可是长期不愈合的伤口脓性分泌物,这些标本留取后应在2小时内送到微生物实验室。

检验科收到合格标本后,将标本接种到相应的培养基(平板)上。血液、脑脊液等注入培养瓶中进行增菌培养5天。


培养基被放到不同培养条件的恒温培养箱中,一般需要培养18-48小时,真菌和一些特殊细菌则需要更长时间。血培养培养期间如果有菌生长,我们会将阳性瓶转种至固体培养基上继续培养,直至长出单个菌落,这个过程也需要18-48小时。如果出现生长不纯的菌落,还需要进一步分纯处理,分纯后的单个菌落才能进行鉴定和药敏试验。这样又会多需要一天时间培养。


在培养基表面长成多种肉眼可见的菌落后,检验人员会根据标本类型、取样部位、菌量等因素排除正常菌群、条件致病菌、污染菌,找出导致感染的可疑致病菌。挑取分离出的单个菌落,通过生化鉴定仪鉴定出细菌的属种。同时进行药敏试验。

我们会根据致病菌的类型,选择合适的药物组合,进行药物敏感性试验,此过程通常需要16-24小时。

药敏结果出来后,老师会根据细菌的耐药机制,对特殊药物耐药要进行复核,这些需要复核试验的结果出来又要加多一天。所以从标本接收到报告发出至少3天时间,对于生长较慢的细菌时间可能会更长。等所有结果出来后,就能形成最终的检验报告。

尿培养正确留取培养出大肠埃希菌